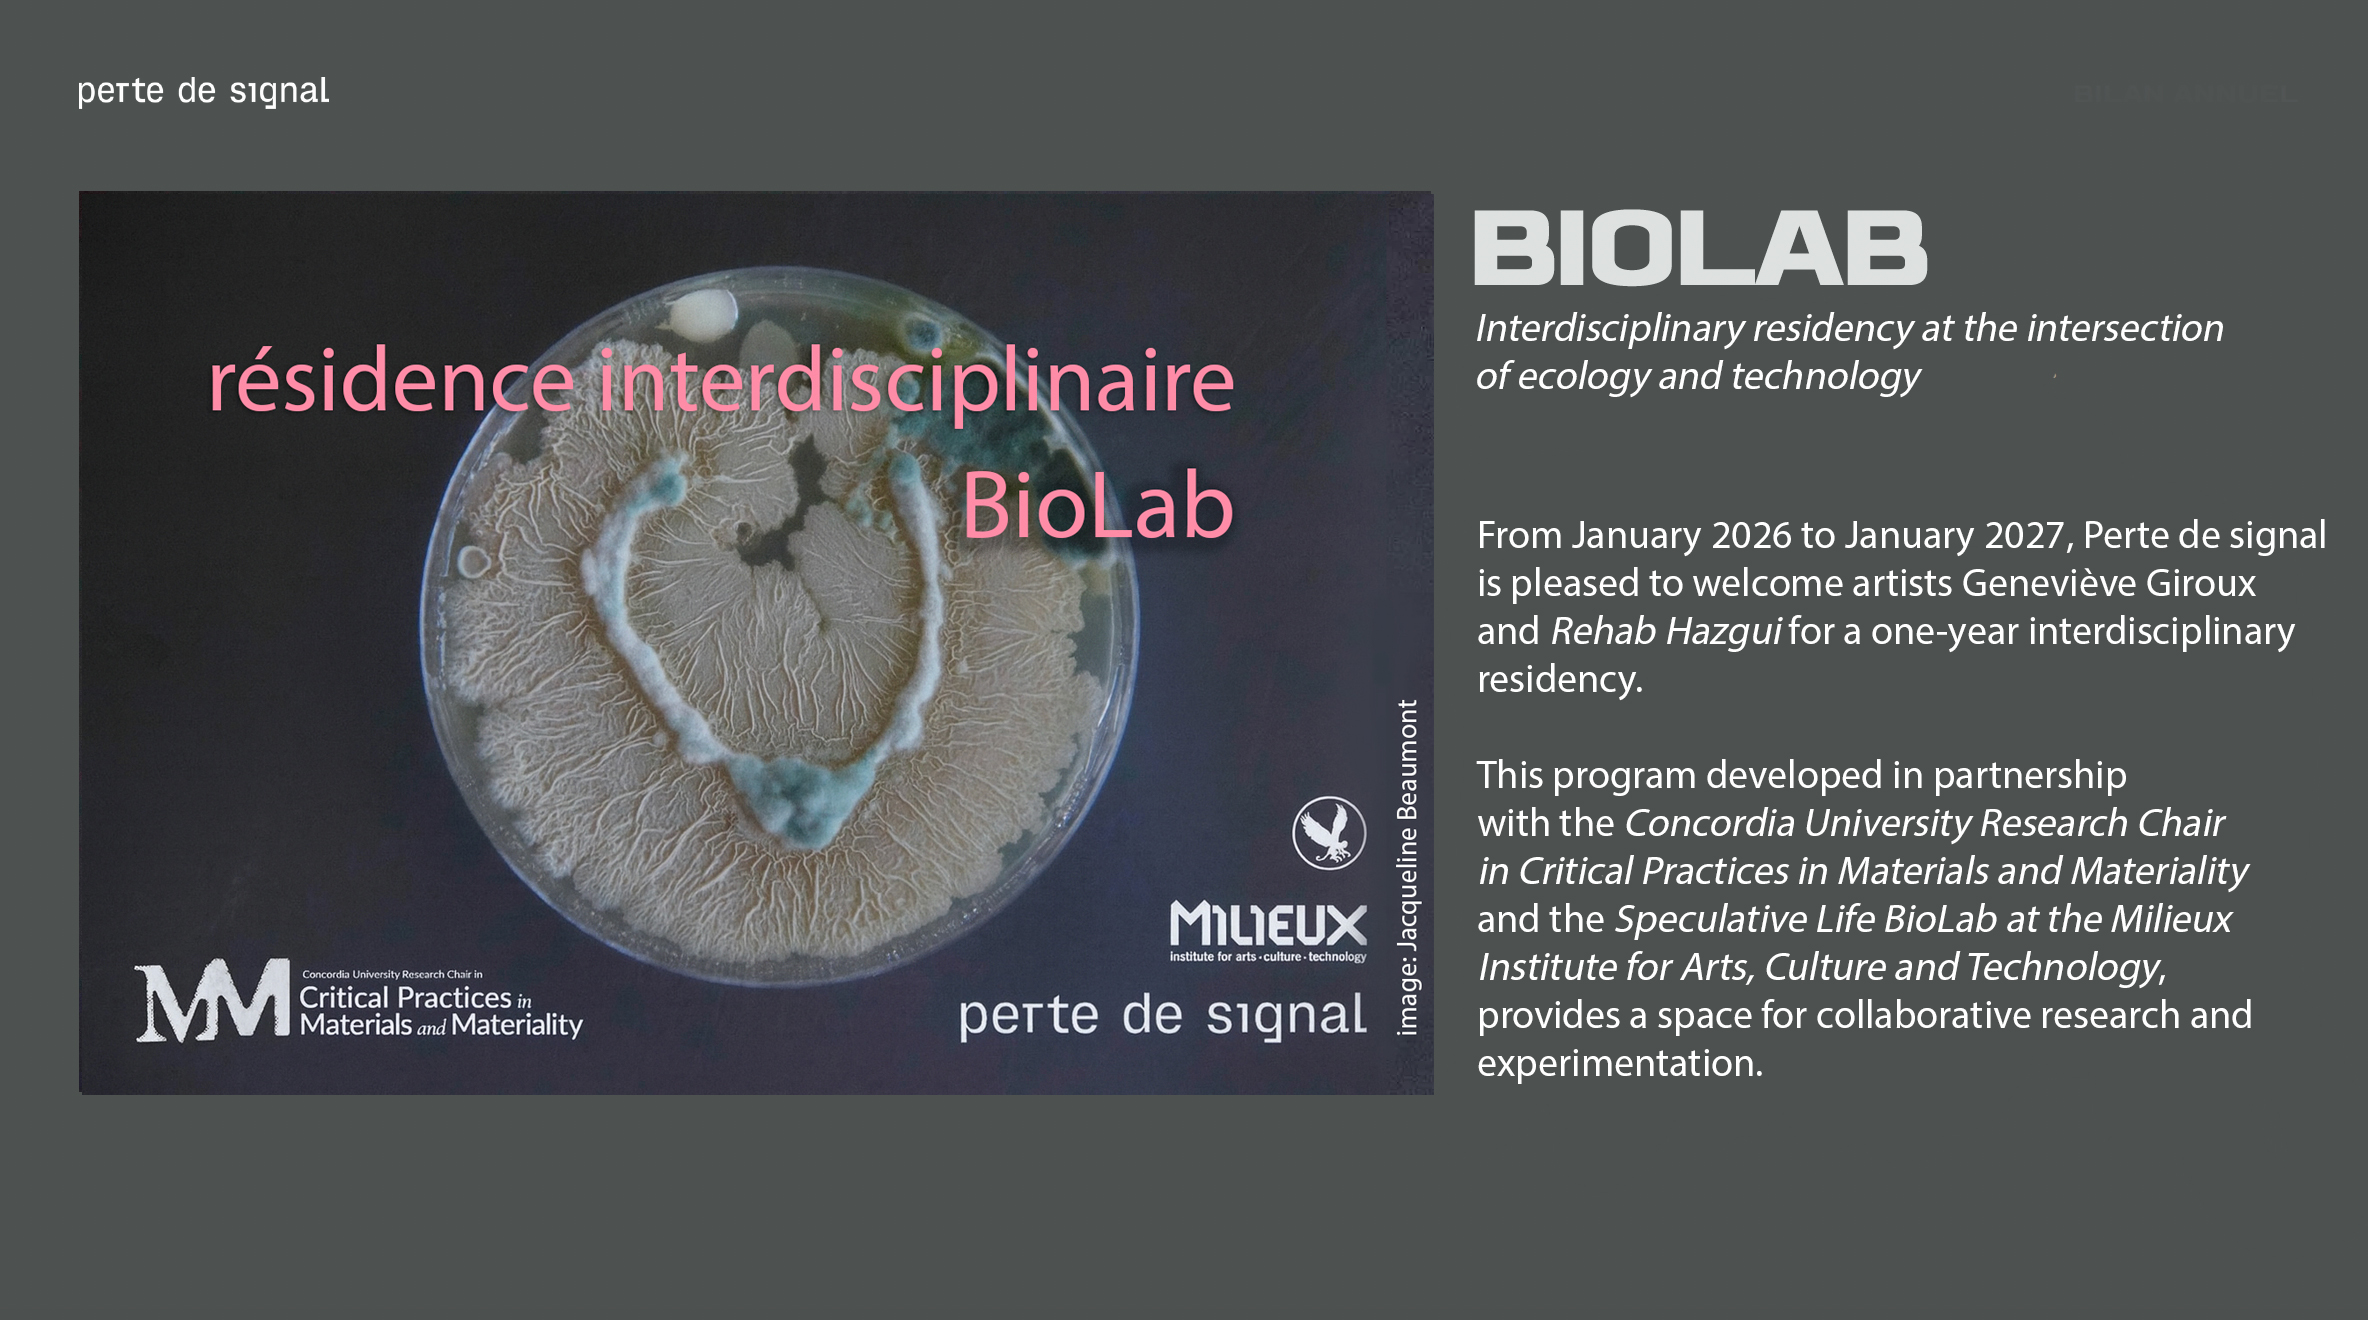

| >: —
Perte de Signal is proud to present ÉPOCHÈ, a series of three performances at rustines_Lab as part of the Rentrée de Gaspé Hivernale 2026, on January 16, 2026, featuring the artists Fumerolles, Nick Rony, and EBB.
This series explores Épochè as a radical act of listening: suspending the habitual meaning of the world to return to pure experience. Each performance offers a different way of undoing our perceptual automatisms, slowing down the flow of meaning, and opening spaces where sound explains nothing but reveals sensitive layers normally invisible.
Presented at rustines_Lab, the ÉPOCHÈ series places the audience and the artists in a singular proximity, where the boundaries between sound, body, and perception are amplified. This intimacy is no accident: it is inseparable from the experience of épochè.
From January 2026 to January 2027, Perte de signal is pleased to welcome artists Geneviève Giroux and Rehab Hazgui for a one-year interdisciplinary residency. This program, developed in partnership with the Concordia University Research Chair in Critical Practices in Materials and Materiality and the Speculative Life BioLab at the Milieux Institute for Arts, Culture and Technology, provides a space for collaborative research and experimentation.
During their residency, the artists will explore the boundary between observation and belonging, questioning the ontology of the living at both microscopic and bioregional scales. Focusing on the Saint Lawrence River, their project will reveal biofilms, microorganisms, sediments, and invisible flows as living microcosms carrying histories and ecological variations. This reserach highlights hidden networks and their dynamics, inviting a perception of life as a relational fabric in constant motion and a contemplation of our interdependence with the living, where aesthetic engagement and ecological awareness mutually reinforce each other.
Geneviève Giroux is an interdisciplinary artist based in Montreal, exploring the invisible ecosystems of life. Through microscopy, scientific photography, generative visualization, video, and archival recordings, she investigates the complex micro-worlds of living organisms. Her practice merges scientific research and artistic experimentation, examining symbiotic networks and adaptive processes. Geneviève treats her creative process as a laboratory, where chance, distortion, and intuitive composition open new ways of seeing.
Rehab Hazgui is a composer, artist, and researcher whose work investigates sound ecology and the bioregional dimensions of landscapes. She interrogates the ontology of the living through sound, revealing the interdependent networks of biological, geophysical, and human systems. Her practice examines how sound emerges from dynamic environments and how conscious listening shapes our perception of space and our relationship to the world. Through compositions and installations, she transforms rivers, sediments, and microorganisms into collaborators in an immersive sound cartography, using movement, repetition, and silence as “third spaces” to explore co-existence and co-evolution.
In process >
We’re continuing our collaboration with Cristo Riffo, Marion Schneider, Philippe Vandal, and Pascale Tétrault to develop, produce, present, and promote their digital art projects. We’re excited to support them on this creative journey, which will culminate in a group exhibition.
This program, designed to support the inclusion of emerging digital artists, provides both logistical and financial assistance to help participants create new works in digital media and the arts.
This edition of Project Emerging is presented in partnership with Molior, whose expertise will enrich the artists’ experience through valuable mentorship and meetings. This support will guide them throughout their creative process.
Next event > spring 2025
Confiture Optronique offers an immersive electronic audiovisual improvisation experience at perte de signal’s rustine_lab. Open to all, regardless of skill level, this jam emphasizes active listening, being present with others, and fully engaging in the moment.
The event encourages the integration of electronic structures that, through their repetitions, dissonances, and transformations, resonate with oral experience. This approach promotes a form of collective improvisation where spontaneity and the emergence of new consensuses are at the heart of the creative process. The goal is to stimulate creative interactions and allow each participant to contribute to the real-time creation of a collective work.
This project is led by Danny Perreault and Alexandre Castonguay, members of Perte de Signal, in collaboration with the center, 3+3+3+4 collective, and mXlab at UQAM.
In process >
Bruire continues with artist duos working in the rustines_lab. Keep an eye out for an Event announcement in the coming months!
Bruire explores the audiographic documentation of four collaborative works between sound artists and visual or video artists. The project investigates how the spontaneity and invisibility of sound waves can be captured, focusing on gesture and sonic materials.
Centered around a model of dispersed, collective virtual listening, the project links the sound and visual dimensions that perte de signal artists frequently work with.